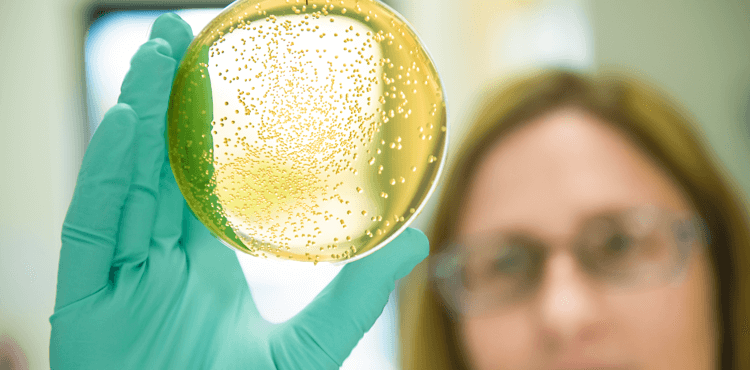
A scientist inspecting a clear, yellow testing product

Discovering What’s Next
A revolutionary approach to cancer therapy. Single tablet regimens for HIV. A cure for hepatitis C.
For more than 30 years, Gilead’s research program has achieved advancements that were once thought impossible. As we bring new products into clinical development, our goal remains the same – to discover, develop and commercialize therapeutics that transform care for people around the world.

Learn More About Our Research Pipeline
Our research and development programs currently focus on potential treatments in HIV, viral hepatitis, emerging viruses, oncology and inflammatory diseases.
Some of the content on this page is not intended for users outside the United States.
